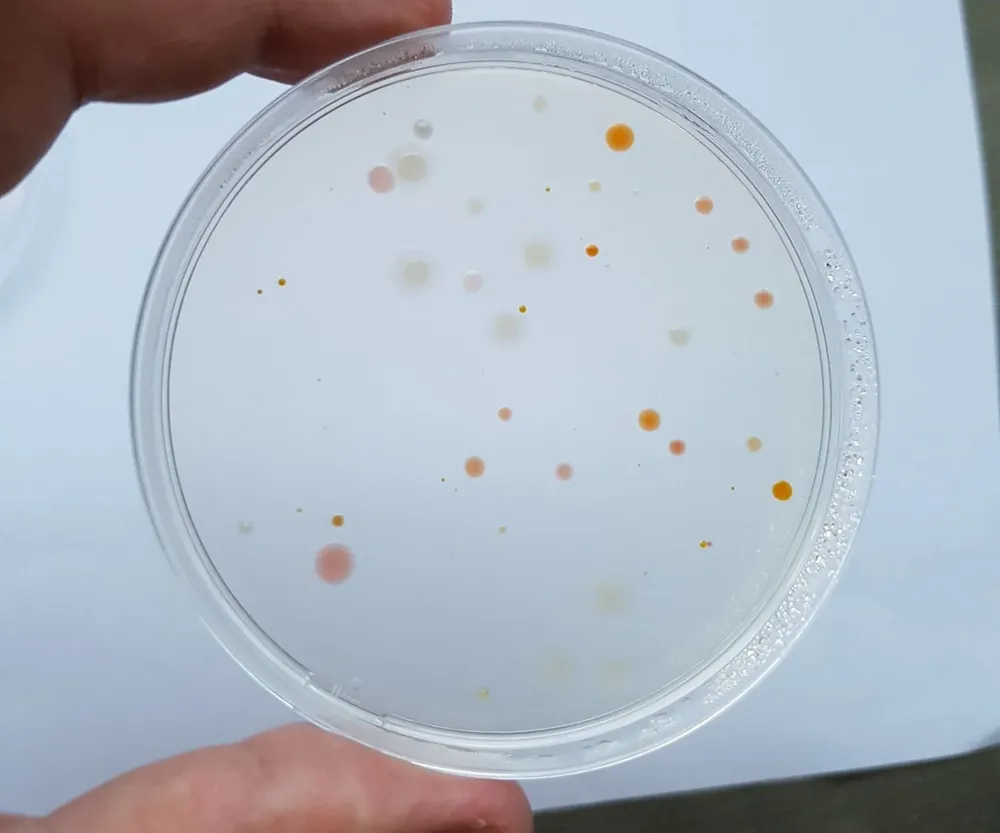
1595989800894.webp

Por Camila Pereira Pastorini - Especial para Cromo
Una bacteria hallada en la Antártida por investigadores de la Facultad de Ciencias de la Universidad de la República lleva un homenaje a José Gervasio Artigas.
El hallazgo es de Javier Menes, investigador de esa institución, que trabaja desde hace dos años como jefe de un proyecto científico del Programa Nacional Antártico.
En el viaje realizado a la Antártida, el científico tomó muestras del aire, cultivó y aisló diferentes bacterias entre las que descubrió más de una nueva.
 Javier Menes
Javier Menes
En principio, Menes y su equipo de trabajo han estudiado a la que denominaron “Hymenobacter Artigasi”; que recibió ese nombre por haber sido aislada muy cerca de la Base Científica Antártica Artigas y en honor al prócer de los orientales.
“Cuando uno describe una bacteria puede estar asignada a un género ya descrito o, según cuán diferente es, se puede proponer crear un género nuevo”, explicó el investigador y agregó que “Hymenobacter”, el nombre del género, ya existía, por lo que “quedaba la posibilidad de asignarle el nombre, que finalmente fue 'Artigasi´”.
La nomenclatura responde a ciertas reglas en las que se exige el uso del latín. Por eso, el nombre no se escribió de la manera en que lo usamos habitualmente.
Hymenobacter Artigasi es un microorganismo caracterizado y descrito en 2019. Como era de esperarse, de acuerdo al lugar donde se encuentra, crece entre 0ºC y 20ºC, siendo los 10ºC su temperatura óptima; lo que la hace atractiva para el uso en ciertas actividades industriales.
Además, la bacteria produce proteínas llamadas enzimas que se utilizan para generar distintas reacciones, ecológicamente amigables, y que son muchas veces preferidas antes que otras reacciones formadas de manera química.
 Javier Menes
Javier Menes
“Esta bacteria tiene muchas propiedades interesantes”, dijo Menes.
Cuando se analizó el genoma, que proporciona toda la información genética del organismo, se observó que el microorganismo produce una sustancia adentro de la célula que le permite defenderse del frío. “Esto puede tener aplicaciones biotecnológicas en la industria de alimentos”, agregó.
Para llegar considerar a la Hymenobacter Artigasi como una nueva bacteria, el equipo de trabajo debió realizar una serie de pruebas. También se observa la forma y otros aspectos físicos y estructurales de la bacteria, además de propiedades de la constitución del organismo. Por ejemplo, los ácidos grasos de la membrana y también propiedades que se encuentran en su genoma.
“El mecanismo para comunicar que se trata de un organismo nuevo es diferente para la microbiología que para registrar otros organismos como vegetales o animales”, contó Menes.
El proceso para que la bacteria sea reconocida internacionalmente como nueva, implica seguir criterios “que te dicen qué tan similar puede ser o no a otras bacterias para decir que estamos frente a una nueva”.
Los resultados de la investigación son enviados a la International Journal of Systematic and Evolutionary Microbiology, una revista científica revisada por pares, que publica mensualmente una compilación de nuevos nombres validados.
Actualmente el equipo de trabajo sigue estudiando a la Hymenobacter Artigasi y sus posibles aplicaciones como lo es la producción de enzimas con las que degradar almidón, agar u otros polímeros.
Entre las otras bacterias encontradas, el científico comentó que hay tres de ellas que son del género Flavobacterio, una Hymenobacter muy relacionada a la Artigasi y otra que probablemente "sea un género nuevo”.
Todas pertenecen al grupo denominado “Extremófilos”, debido a las condiciones extremas en las que viven. En este caso esas circunstancias son a causa de la temperatura pero también por la alta radiación ultravioleta a la que se ven sometidas y para las que tienen mecanismos de protección.
 Javier Menes
Javier Menes
Efectos del metano
El hallazgo surgió mientras Menes y su equipo desarrollaban el proyecto “Ciclo biogeoquímico del metano”; una propuesta presentada y aprobada por el Instituto Antártico hace dos años.
Las islas del sur antártico gozan de un clima más ameno y están rodeadas por lagos permanentes y otros que se forman en verano por el derretimiento de la nieve, por lo que, estudiar cómo se emite el gas metano en los lagos de la península donde se ubica la base antártica uruguaya, permitiría conocer nuevas formas de reducir sus efectos negativos como lo es el efecto invernadero.
“Hay depósitos de metano que son de origen mineral. Son procesos habituales”, dijo Menes quien agregó que la importancia de las lagunas radica en que en el fondo de éstas, los microorganismos que producen el metano son capaces de desarrollarse sin necesitar de oxígeno. “Necesitan este tipo de ambiente”, explicó.
En Uruguay hay preocupación por la generación del gas porque tenemos grandes extensiones de cultivo de arroz y un importante número de rumiantes que expulsan metano al contener estas bacterias en su sistema digestivo.
“El desprendimiento de metano está estudiado en los lagos del norte, pero en la Antártida no había sido estudiado”.
El proyecto abarca el estudio de los microorganismos que producen metano y que lo liberarían a la atmósfera y otro tipo de microorganismos que pueden utilizar ese gas como fuente de energía y fuente de carbonos.
Estudiar la zona del planeta que ha sufrido mayor aumento de temperatura en los últimos cien años (3ºC) puede ayudar a conocer sobre la “influencia de temperatura en la emisión de metano”, concluyó.